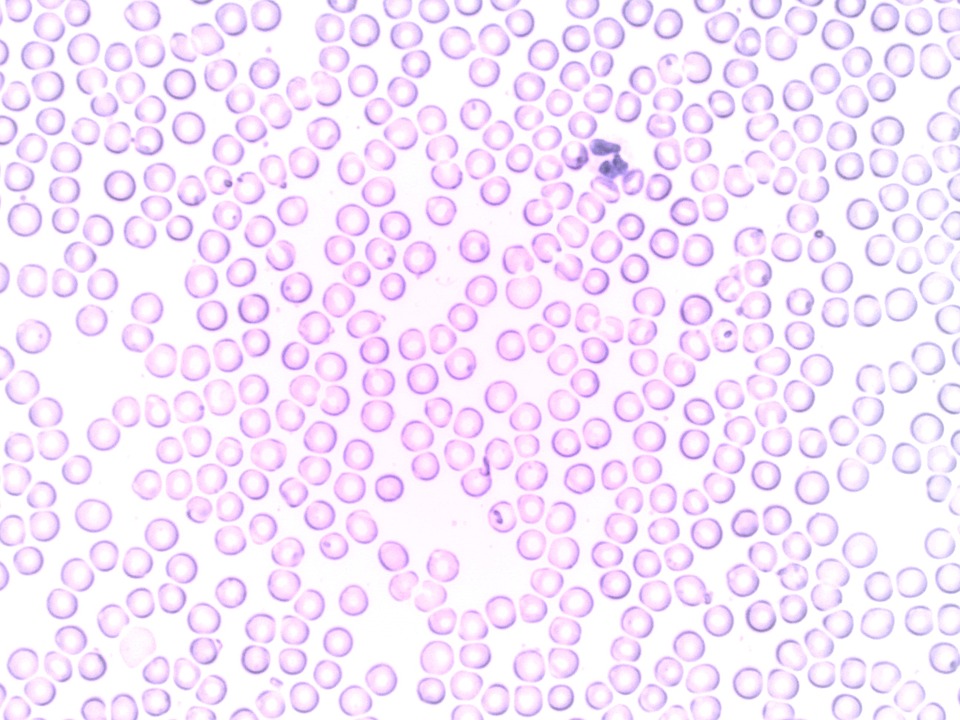

0
6978
0
声明:水印不代表署名仅用于防盗,版权归上传人所有,购买后下载素材无水印。
VIP 血液 嗜中性白细胞 分段的中性粒细胞 - 上的免费照片
ID:3216074图片
类型
3216074
作品编号
910 kB
文件大小
JPG
文件格式
2592X1944
分辨率
2022-11-19T02:46:29
上传时间
万图聚网所有作品均是用户上传分享并拥有版权或使用权,仅供网友学习交流,未经授权,禁止商用!素材版权归原作者所有,若您的权利被侵害,请联系 admin@wantuju.com。
授权范围: 可做商用 不要求署名
授权方式: CC0授权 海外免版权素材,正版放心商用
















